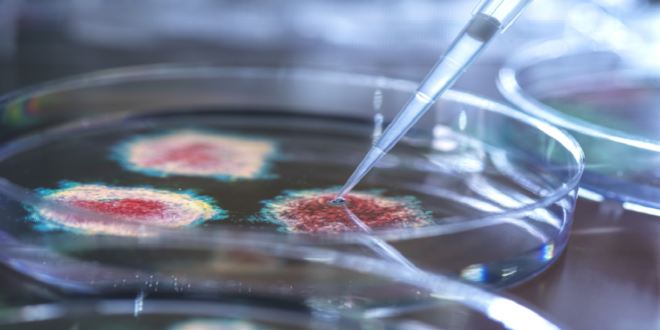

منبر العراق الحر :
اكتشف فريق من العلماء فيروسا قاتلا في ولاية ألاباما الأمريكية، ما أثار مخاوف من احتمالية انتقاله إلى البشر عبر مستودعات الحيوانات، وهو ما قد يؤدي إلى تفشّ وبائي واسع النطاق.
وحدد العلماء فيروس “كامب هيل” في حيوان الزبابة بالولاية، الذي ينتمي إلى عائلة فيروسات الهينيبا، بما في ذلك فيروس نيباه، المعروف بانتقاله عبر الخفافيش وقدرته على قتل ما يصل إلى 70% من المصابين به. ومع ذلك، لم تسجّل حتى الآن أي إصابات بشرية بفيروس كامب هيل، ولا يزال العلماء يجهلون أعراضه المحتملة أو معدل الوفيات الناجم عنه.

وحذّر الدكتور ريس باري من جامعة كوينزلاند، الذي أكد اكتشاف الفيروس، من إمكانية انتقاله إلى البشر، قائلا: “يشير هذا الاكتشاف إلى احتمال انتقال الفيروس من الزبابة إلى الإنسان، وهو أمر يثير القلق. كما أن العثور على فيروس من عائلة هينيبا في أمريكا الشمالية يعد اكتشافا بالغ الأهمية، لأنه يوسع نطاق فهمنا لانتشار هذه الفيروسات عالميا”.
وأفاد تقرير علمي حديث بأن فيروس كامب هيل قد يشكّل تهديدا محتملا للصحة العامة، نظرا لمعدلات الوفيات المرتفعة المرتبطة بفيروسات الهينيبا. ومع ذلك، شدد العلماء على الحاجة إلى مزيد من البحث لتحديد مدى خطورته على البشر.
وكشف باري أن فيروسات الهينيبا تسببت في أوبئة خطيرة ووفيات في مناطق مختلفة من العالم، موضحا أن أخطر هذه الفيروسات تشمل: فيروس هندرا الذي اكتُشف لأول مرة في بريسبان، أستراليا، ويبلغ معدل وفياته 70%. وكذلك فيروس نيباه الذي تسبب في تفشي أوبئة في جنوب شرق آسيا، بما في ذلك ماليزيا وبنغلاديش، بمعدلات وفيات تتراوح بين 40% و75%.
وتؤدي هذه الفيروسات إلى أعراض شديدة تشمل: الحمى وضيق التنفس والالتهاب الرئوي. كما قد تؤدي بعض الحالات إلى التهاب في الدماغ ونوبات صرع وغيبوبة وتدهور صحي سريع. ولا يوجد حتى الآن علاج محدد لهذه الفيروسات.
وأدى العثور على فيروس كامب هيل في الزبابة، وليس الخفافيش، إلى إعادة النظر في افتراضات العلماء حول مضيفاته الطبيعية وانتشاره الجغرافي. وتعيش الزبابة الشمالية قصيرة الذيل في الغابات الكثيفة والمستنقعات بأمريكا الشمالية، حيث يتداخل موطنها مع مناطق مأهولة بالسكان، ما يزيد من احتمالية انتقال الفيروس إلى البشر.
ورغم أن الاكتشاف يعود إلى عام 2021، إلا أن التقرير العلمي نُشر مؤخرا. ولم يُعثر على الفيروس في أي حيوان آخر غير الخفافيش سابقا، ولم يسجل انتقاله إلى البشر حتى الآن.
وأوضح الدكتور أرييل إسحاق، أحد معدي الدراسة، أن الفريق العلمي يركز حاليا على تطوير لقاحات ضد هذه الفيروسات. وأضاف أن فيروسات الهينيبا تدخل الخلايا عبر بروتينات سطحية معينة، ما يجعل دراستها ضرورية لفهم كيفية انتشار الفيروس وإيجاد وسائل لمكافحته.
ويعتزم العلماء مواصلة دراسة التركيب البروتيني للفيروس، بهدف تطوير استراتيجيات وقائية فعالة، قد تساعد في حماية البشر من أي تهديد مستقبلي محتمل.
المصدر: ديلي ميل
 منبر العراق الحر منبر العراق الحر
منبر العراق الحر منبر العراق الحر